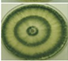
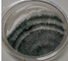

Highlights
Information is provided on the use of Trichoderma spp. as an alternative to chemical pesticides.
General and non-specialized information on the use of Trichoderma spp. is presented to Mexican farmers.
The diversity of autochthonous Trichoderma species in Mexico is described.
Commercial products based on Trichoderma in Mexico are listed and described.
Introduction
Agriculture is the most important activity for human nutrition. The modern agricultural model has increased its productivity; however, since it is based on the use of pesticides, its sustainability is questioned, due to the series of ecological, economic and health impacts that they cause (Sarandón & Flores, 2014). For this reason, sustainable food production is a challenge for humanity, which requires transforming conventional forms of production to achieve increases in crop yields and quality and to minimize the negative impact of pesticides on the environment (López, Pelagio, & Herrera, 2015).
In Mexico, agricultural production during recent decades has favored the development of corporate farming, characterized by specialized monocultures, in which the intensive use of highly toxic pesticides is the dominant way to counteract the pests and diseases that affect them (González, 2014). Restricting the use of chemical pesticides would result in lower yields and higher food prices (Storck, Karpouzas, & Martin-Laurent, 2017).
The potato (Solanum tuberosum L.) crop is of great economic importance since it is the third most consumed food in the world (Organización de las naciones unidas para la agricultura y la alimentación [FAO], 2021), and, in Mexico, its yield is affected by phytopathogens such as Phytophthora infestans Mont De Bary, which causes late blight, one of the most devastating potato crop diseases (Kerroum, Noureddine, Henni, & Mabrouk, 2015). The most widely used method to control this and other diseases is chemical, with effective results, but with residual effects due to the accumulation of toxic substances in water bodies, soil, plants and animals (Miller & Johnson, 2000). Concern about the damage caused by the excessive use of synthetic pesticides has led to a widespread rejection of chemical pest control in agriculture (Sarwar, 2015).
Although the symptoms of acute poisonings are well characterized, prolonged exposure to subclinical concentrations is a cause for concern as it is associated with cognitive impairment, reproductive disorders, cancer, diabetes, neurobehavioral disorders, and congenital malformations, as well as cardiovascular, respiratory, and neurodegenerative diseases, such as Parkinson's disease (Mostafalou & Abdollahi, 2017).
Biological control is based on the reduction of plant pests and diseases through the use of natural organisms called biopesticides, which contribute to integrated crop management and avoid, where possible, the use of agrochemicals that are toxic to the environment. These organisms are known as antagonists and are the subject of various studies in many fields of agricultural research. There is a great diversity of biological control agents in ecosystems, so it is necessary to isolate them in order to put them into use (López et al., 2015). Some of their advantages are low production costs, long-lasting permanence in the soil once established, beneficial effects on non-pathogenic organisms, crop health, and safety in plants, animals, and humans (Ghazanfar, Raza, Raza, & Qamar, 2018). However, they are difficult to reproduce and establish in crops, are highly specific, and are not systemic, in addition to which exotic agents can displace native organisms and become pests (Companioni-González, Domínguez-Arizmendi, & García-Velasco, 2019).
Trichoderma spp. are cosmopolitan fungi that occur naturally in soil and offer several benefits to crops, such as nutrient solubilization (Igiehon & Babalola, 2018), tolerance to abiotic and biotic stresses (Stringlis, Zhang, Pieterse, Bolton, & Jonge, 2018), and induction of defense systems in plants (Malmierca et al., 2015). These fungi interact as symbionts, suppress the growth of phytopathogens with direct mechanisms (such as parasitism and antibiosis), compete for space and nutrients, and interfere with the respiration mechanism of pathogens by producing waste metabolites such as hydrogen cyanide, ammonia and carbon dioxide; in addition, they participate in the physicochemical blocking of soil pores (Ghazanfar et al., 2018).
Trichoderma species have been studied for decades as antagonists of phytopathogenic fungi and insects; however, it wasn’t until the beginning of this century that their commercialization as biofungicides began, thanks to the change in the agricultural model that demands obtaining healthier foods with a lower chemical residue content (Pineda-Insuasti et al., 2017). Thus, with Trichoderma spp. products marketed worldwide, organic agriculture and the reduced use of chemical pesticides are promoted (Haas & Défago, 2005).
It is necessary to consider that phytopathogens have some natural biological antagonist that is native to the soil, so it is suggested that native strains are more effective than imported ones (Martínez et al., 2008). In this sense, success in the formulation and commercialization of preparations based on Trichoderma spp. for Mexican agriculture requires studies on the selection of promising native isolates, whose use contributes to sustainable development that allows responding to the demand for food products (Companioni-González et al., 2019).
This paper is a literature review of the antagonistic fungus Trichoderma spp., which can control phytopathogens that affect different crops, as well as of its multiple benefits and the native microorganisms belonging to its genus that are registered in Mexico. Therefore, the aim of this review was to gather information concerning the antagonistic fungus Trichoderma spp., its taxonomy, ecology, use as biological control, isolation, culture, morphological and molecular identification, modes of action, and, briefly, the distribution of native species in Mexico and the availability of some national and international commercial products.
Methodology
For this literature review of Trichoderma, information was obtained from the Agris, BioOne, Elsevier, Google Scholar, Redalyc, SciELO, and Scopus databases. The keywords used were Trichoderma spp. in combination with antagonistic microorganisms, mycoparasitism, antibiosis, secondary metabolites, native microorganisms and commercial products. A total of 154 citations were obtained, of which 114 were consulted. In selecting the articles, emphasis was placed on agricultural, environmental, ecological, genetic, geographical, horticultural and social criteria.
Taxonomy
Fungi of the genus Trichoderma spp. descend from the following lineage: Eukaryota domain, Opisthokonta supergroup, Fungi kingdom, Dikarya superdivision, Eumycota subkingdom, Ascomycota division, saccharomyceta subdivision, Pezizomycotina subdivision, leotiomyceta subdivision, Sordariomycetes class, Hypocreomycetidae suborder and Hypocreaceae family. They are saprophytes, have mycelium with simple septa, reproduce asexually, are haploid, and their wall is composed of chitin and glucan (Companioni-González et al., 2019). At the beginning of the use of Trichoderma spp. about 30 species were identified; currently, with molecular biotechnology, more than 100 species have been distinguished (Torres de la Cruz et al., 2015).
Ecology
Trichoderma spp. are common in decaying bark and on the surface of plant roots (Carreras-Villaseñor, Sánchez-Arreguin, & Herrera-Estrella, 2012). Their success in the ecosystem as natural decomposers is thanks to their high enzymatic capacity to degrade substrates (Companioni-González et al., 2019), their accelerated growth capacity, their nutrient absorption capacity, and their survival in soils with different adverse environmental conditions and amounts of organic matter, as well as to being facultative anaerobes and having a destructive tendency on phytopathogenic microorganisms. All the above allows them to show greater ecological plasticity (Infante, Martínez, González, & Reyes, 2009). Some Trichoderma species have a characteristic coconut odor, produced by volatile compounds (Tsai, Tzeng, & Hsieh, 2008).
Trichoderma spp. fungi are widely distributed in almost all soil types except at the poles (Singh et al., 2014). They occur mostly in acid soils (Brotman et al., 2013), in forest or agricultural soils (where they account for up to 15 % of the total fungal propagules), and in grassland soil (with 3 %) (Hagn, Pritsch, Schloter, & Munch, 2003). These fungi are made up of species and strains with different functions that can be found in a wide variety of ecological niches. They have low nutritional requirements, and for their growth they need a temperature range of 25-30 °C (Sandle, 2014). Climate affects their distribution, so the species Trichoderma hamatum B. is tolerant of excess humidity, Trichoderma harzianum R. is favored in warm climates and Trichoderma viride P. prefers cold temperatures (Sarhy-Bagnon, Lozano, Saucedo-Castañeda, & Roussos, 2000).
To combat soil phytopathogens, Trichoderma spp. require physiological and environmental factors, such as carbon sources (sodium acetate, starch, maltose, glucose, mannose, fructose, inositol, galactose, sodium citrate, xylose, arabinose, lactose, pectin, polyglycolic acid, ribose and malic acid), optimum pH between 4.5 and 7.5, temperatures between 20 and 37 °C, nitrogen sources (such as calcium nitrate, potassium nitrate, sodium nitrite, sodium nitrate, ammonium sulfate, monoammonium phosphate, ammonium chloride and ammonium nitrate) (Jayaswal, Singh, & Lee, 2003) and darkness, as they are extremely sensitive to light (Steyaert, Weld, Loguercio, & Stewart, 2010). They have high adaptability to ecological conditions, since they can grow exclusively as a saprophyte or interact with animals and plants (Zeilinger, Gruber, Bansal, & Mukherjee, 2016). They exhibit rapid development and can produce structures that tolerate unfavorable environmental conditions and lack of food (Companioni-González et al., 2019). Considering the above, nutrition, substrate and the environment play an important role in multiplication and mycelial growth in Trichoderma spp. (Romero-Arenas et al., 2012), characteristics to be taken into account for their selection for use in Mexican agriculture.
Trichoderma spp. as a biological control
Biocontrol is defined as the use of living organisms to combat agricultural pests and pathogens (Hajek & Eilenberg, 2018). It can also be defined as the control of one organism by another organism, or the control of a causal agent of a disease by an antagonistic microorganism (Bettiol, Maffia, & Castro, 2014). For 60 years, Trichoderma spp. have been known as biological control agents against plant pathogenic fungi (El Komy, Saleh, Eranthodi, & Molan, 2015). Woo et al. (2014) note that Trichoderma spp. are the most widely used biological control agents against a broad spectrum of root and shoot pathogens. Likewise, their ability to reduce toxic compounds, accelerate the degradation of organic matter (Vázquez, Barrera, & Bianchinotti, 2015), and develop on diverse substrates with good organic matter content has been demonstrated, which facilitates their mass production for agricultural use (Agamez-Ramos, Zapata-Navarro, Oviedo-Zumaqué, & Barrera-Violeth, 2008).
As a biological control, fungi of the genus Trichoderma are present in the soil, and due to their antagonistic actions, they act as parasites, which have demonstrated their effectiveness against pathogens responsible for root infection and the incidence of rot in plants. These actions can be classified as: mycoparasitism (with the secretion of hydrolytic enzymes that act on the cell wall of the host), antibiosis (with the synthesis of antimicrobial secondary metabolites), competition for space or nutrients (with the production of metabolites that interfere with the development of pests) and symbiosis (by favoring growth and inducing resistance to diseases and abiotic stresses in the plants with which they coexist). Trichoderma spp. decompose organic matter, so they are considered environmental opportunists, and they have a wide geographical distribution, rapid growth that favors the colonization of their habitats, and a high capacity to parasitize or prey on other fungi. In addition, these fungi can grow in soils without crops, as well as suppress structures and create resistance to existing pathogens, so they can act not only in a curative way but also to prevent diseases (Nascimento et al., 2022). They take nutrients from the fungi they parasitize and from the organic material available in the soil, which favors their decomposition and the proliferation of the fungus (Agamez-Ramos et al., 2008).
Trichoderma spp. are associated with the rhizosphere of plants or are endophytes, so they can promote plant growth and development through the production of organic acids (such as indoleacetic acid [auxins], gibberellic acid [gibberellins], gluconic acid, fumaric acid, and citric acid), and lower soil pH. They promote solubilization of minerals such as phosphorus, iron, magnesium and manganese, which are vital for their metabolism (Sharma, Salwan, & Sharma, 2017). As an example, seed treatment with Trichoderma spp. has been a successful technique that ensures that the root is colonized, which benefits the plant (Xue et al., 2017).
It should be noted that not only the biocontrol agent used is important, but also the way it is applied. Alves-de Aguiar, Gomes-da Cunha, and Lobo (2014) exposed the antagonism of several Trichoderma spp. against Sclerotinia sclerotiorum L. in tomato (Lycopersicum esculentum M.) hybrid Heinz 7155, where the biofungicide was applied by drip irrigation, which favored disease control and increased fruit yield. Charoenrak and Chamswarng (2016) applied Trichoderma asperellum S. L. & N. in pellet form to combat seed discoloration disease in rice (Oryza sativa L.) in Thailand, and found that their formulations increased plant height, number of stems, seed weight, and total yield compared to the untreated control; in addition, they reduced the severity of the disease in the plants.
It is necessary to consider that Trichoderma spp. are not only beneficial fungi, since, in edible fungi, such as mushrooms, they cause green mold disease (Aydoğdu, Kurbetli, Kitapçı, & Sülü, 2020). Trichoderma viride P. as a pathogen causes mortality in Austrian pine seedlings (Li Destri-Nicosia, Mosca, Mercurio, & Schena, 2015), while Trichoderma brevicompactum K. produces mycotoxins that cause harm in humans, namely vomiting and gastroenteritis (Yang, Yu, Tan, Liu, & Wu, 2017).
Isolation and culture
Because Trichoderma spp. are microorganisms that preferentially inhabit soil (Singh et al., 2014), to isolate them they can be recovered from soils with a high organic matter content. Samples are obtained from the soil at random, with two different ways of sampling: systematic or unsystematic. The first, with simple random or stratified random schemes, would be suitable for uncultivated land or plots and for extensive crops, while for crops in plots or tree plantations, zig-zag, staggered, X or grid schemes can be used. The latter would be used when there is no special design (Sadeghian, 2018).
To obtain a homogeneous sample from the site, several soil subsamples must be taken, which can be at ground level, at the neck of the plant, in the area or under the root; subsequently, the subsamples are mixed and a sample is extracted. For depth, the type of crop and the depth of its roots are taken into account. Procedures, tools and materials can be chosen according to the researcher's criteria (Acurio & España, 2017; Mendoza & Espinoza, 2017; Sadeghian, 2018). For in vitro culture, there are different methods, such as serial dilution, which favors spore isolation, and does not favor other fungi that grow rapidly as mycelium on soil particles (Karthikeyan, Jaleel, Lakshmanan, & Deiveekasundaram, 2008; Maniscalco & Dorta, 2015; Magalhães-de Abreu & Heinrich, 2022). For bacterial growth inhibition, an antimicrobial agent is added to the culture, such as 0.025 mg∙mL-1 chloramphenicol (Sigma) (Vulgarin-Martínez, 2006; López-López et al., 2023).
Morphological characteristics
Macroscopic characterization is performed by observation with the naked eye or with the aid of a stereoscope, and taxonomic keys are used for their description, such as those of Barnett and Hunter (1972), and Samuels and Hebbar (2015). Visual morphology would be the color of the colony (green with different intensities according to the species, white or yellow), the cottony texture or not of the mycelium, the formation of two or more concentric rings constituted by green pigmented conidia, and the diameter of the colony.
Microscopic characteristics are determined using optical microscopy, considering the taxonomic keys of Barnett and Hunter (1972), Gams and Bissett (1998), and Samuels and Ismaiel (2011) that define them, such as their hyaline and septate hyphae, the length and type of branching of their conidiophores, the shape, size, arrangement and number of phialides, and the shape, texture and dimension of conidia, as well as of their chlamydospores. Waghunde, Shelake, and Sabalpara (2016) state that the genus Trichoderma has about 200 species and that the strains appear very similar in terms of the color and texture of their mycelium, with or without concentric rings in two or more numbers, and their green color in different shades.
Molecular identification
Trichoderma species were identified considering morphological and physiological differences with the established taxonomy. However, this identification is not totally satisfactory, since the plasticity of the morphological characteristics in Trichoderma species is not sufficient to make an accurate taxonomic diagnosis. Therefore, for accurate identification, it is necessary to use molecular analyses (Hermosa, Viterbo, Chet, & Monte, 2012), as shown in Table 1.
Table 1 Morphological and molecular identification of Trichoderma strains isolated from different regions and crops.
| Strain | Identification | Origen and crop | Accession no. | Reference | |
|---|---|---|---|---|---|
| Morphological | Molecular | ||||
|
Trichoderma harzianum R. | Trichoderma asperellum S. L. & N. | Chihuahua, Mx. Capsicum annuum | EU598544.1 | Guigón-López et al. (2010) |
|
Trichoderma viride P. | Trichoderma asperellum S. L. & N. | Guerrero, Mx. Mangifera indica | GU198303.1 | Guigón-López et al. (2010) |
|
Trichoderma spp. | Trichoderma asperellum S. L. & N. | Sinaloa, Mx. Solanum tuberosum | AY380912 | Matas-Baca et al. (2022) |
|
Trichoderma asperellum S. L. & N. | Trichoderma asperellum Q1 S. L. & N. | China Cucumis sativus | HQ293149 | Qi & Zhao (2012) |
|
Trichoderma spp. | Trichoderma longibrachiatum R. | Colima, Mx. Mangifera indica | EU401572.1 | Guigón-López et al. (2010) |
Molecular biology is a scientific discipline that studies living beings at the molecular level. For the Trichoderma fungus, a sample of the mycelium is used to check for certain genes, proteins, or other molecules that specifically identify the species of the genus. The fungal constant is based on DNA sequencing, but also on the use of various gene markers that are used for correct molecular identification (Xu, 2016).
Fungi of the genus Trichoderma can be molecularly identified by the internal transcribed spacer (ITS) region’s elongation factor, also called ribosomal DNA oligonucleotides. However, Trichoderma forms species complexes, which increases the importance of obtaining correct identification; for this, the translation elongation factor encoding gene (TEF1-α) or the RNA polymerase II subunit (RPB2) is also sequenced (RPB2) (Gu, Wang, Sun, Wu, & Sun, 2020). Also, genetic distances between species can be measured using inter-simple sequence repeats or ISSRs, which have been shown to be useful for defining genetic relationships between Trichoderma strains. This is important to discover diversity, not only between species but also within species (Umaña-Castro, Orozco-Cayasso, Umaña-Castro, & Molina-Bravo, 2019). Today, laboratory methods and techniques for molecular identification are performed as a routine procedure in almost all phytosanitary diagnostic laboratories.
Genomic DNA extraction
This technique consists of isolating DNA molecules from fungal tissues, and is based on their physicochemical characteristics to precipitate their DNA (Lázaro-Silva, de Mattos, Castro, Alves, & Amorim, 2015). The genomic DNA of each strain is extracted from fresh mycelium, which is generally grown in a culture medium such as PDA (potato, dextrose and agar); after its growth, various techniques for its extraction are carried out, such as those described by Rajendrakumar et al. (2006), Zhang, Zhang, Liu, Wen, and Wang (2010), Hernández-Domínguez et al. (2019), Morales, Lino, Ortega, and Castellanos (2020), Küpper, Steiner, and Kortekamp (2022), and Barboza-García, Pérez-Cordero, and Anaya-Chamorro (2022), among others.
DNA amplification
With the polymerase chain reaction (PCR) technique in a thermal cycler, DNA sequences are amplified for identification. This technique is a simple and fast way to obtain millions of copies of the DNA present in biological samples (Mas et al., 2016). To amplify the ITS region of the DNA sample, gene fragments TS4 and ITS5 can be used (White, Bruns Lee, & Taylor, 1990); for the translation elongation factor 1-α (TEF1-α), fragments EF1-728F and TEF1LLErev can be used, and for RNA polymerase II Subunit B (RPB2) genes, fragments RPB2-5F and RPB2-7R can be used (Gu et al., 2020). Subsequently, to separate and observe the DNA or RNA molecules from the products obtained in the amplification, the laboratory technique called electrophoresis is used, and depending on their size and the resolution we want to obtain, agarose or polyacrylamide gels can be used at different concentrations. Observation is made by means of an X-ray with the aid of an ethidium bromide solution, an ultraviolet light lamp or silver staining. The separation of the molecules (DNA, RNA or proteins) is carried out based on their size and electrical charge, depending on their concentration in base pairs (Fierro, 2014; Mas et al., 2016).
Amplified DNA sequencing
According to Márquez-Valdelamar, Serrato-Díaz, and Cerritos-Flores (2008), genome sequencing is performed using different methods and techniques to determine the order of the nucleotides in the amplified DNA. These are based on the fact that all living beings have a fundamental divergence between the molecules of their genetic material. The amplified products are visualized by horizontal electrophoresis in 2% agarose gels (Acuña, Yalta, & Veli, 2020) and separated in a genetic analyzer. The sequencing process ends with the analysis of results in an electropherogram that shows the sequences obtained.
Capillary electrophoresis (CE) is another method that consists of the separation of compounds by an electric field, but in a capillary usually made of fused silica with electrolytes. An electrical double layer is formed in the capillary as part of the transport phenomenon that occurs inside it, and this offers greater versatility and efficiency, shorter analysis times, lower reagent consumption, and lower cost columns (Tomás-Barberán, 1995; Suntornsuk, 2002; Wu, Yu, Li, & Li, 2018).
Sequence comparison
Once the ITS or TEF1-α sequence of interest has been obtained, it is necessary to compare them with sequences available in electronic databases to determine their phylogenetic relationship; one of these databases is GenBank (gene bank) (Benson et al., 2018). The comparison is made in computer programs that use different search algorithms, where the most used is BLAST (basic local alignment search tool, http://www.ncbi.nlm.nih.gov), with which it is possible to observe whether the fragment generated is already sequenced or is a new species (Márquez-Valdelamar et al., 2008).
Sequence registry
The purpose of this step is to create a right for the discovering researcher and to identify the microorganism found. Since 1995, molecular identification has been used in many lines of research, generating so many sequences that, in the early 1980s, it was necessary to create universal databases to safeguard the information and make it accessible to users. In 1982, GenBank was created, through the National Center for Biotechnology Information (NCBI), with more than 2,000 sequences and, at the beginning of 2011, this database consisted of more than 100,000,000 sequences (NCBI, 2021). According to GenBank version 250.0 documentation, as of June 2022 the database contained more than 2.45 billion sequences (GenBank, 2022).
Phylogenetic tree
A phylogenetic tree is a simple figure of biological associations connected by common descent, by major taxonomic groups or species. Most trees are created from DNA, RNA or protein molecular data (Gregory, 2008).
Phylogenetic or cladistic systematics is a branch of biology that detects, describes and explains the organization and origin of the diversity of organisms (Moritz & Hillis, 1996). This is based on molecular sequences, and has allowed grouping Trichoderma spp. within incomprehensible species, since they are genetically similar species, even though they are morphologically indistinct strains (Allende-Molar, Báez-Parra, Salazar-Villa, & Rojo-Báez, 2022).
Computer programs are needed to obtain a phylogenetic tree, then the forward and reverse sequences are checked and aligned in BioEdit 7.0.9 (Hall, 1999) and ClustalW (Thompson, Higgins, & Gibson, 1994) to obtain a consensus sequence, then the sequences are analyzed with PAUP 4. 0-10 (Swofford, 1998), the Neighbor Joining method (Saitou & Nei, 1987) and Felsenstein's Bootstrap (1985), and finally they are passed to the FigTree 1.4.3 program (Rambaut, 2016) to edit the dendrogram, which is the basis for the analysis of behavioral and ecological biogeographic patterns in the evolutionary framework of the species (Espinosa-de los Monteros, 2003). In phylogenetic tree analysis, Bayesian inference is an intuitive and non-deductive tool, which focuses on the confidence of the observations for decision-making on the validity of its results, that is, the proximity between clades in the dendrogram, which can define the closest identification to the species studied (Rendón-Macías, Riojas-Garza, Contreras-Estrada, & Martínez-Ezquerro, 2018).
Antagonistic modes of action
Fungi of the genus Trichoderma provide mechanisms for plant protection in two ways: 1) directly, when they exert mycoparasitism, antibiosis, and competition for space and nutrients on pathogens, and 2) indirectly, when the fungus induces an increase in plant protection systems so that plants can defend themselves against pathogens (Guzmán-Guzmán et al., 2023).
Parasitism
Parasitism constitutes a mechanism for inhibiting the growth of phytopathogens, in which the parasite provides itself with nutrients when it kills its prey, although it does not always eliminate the pathogen (Guzmán-Guzmán et al., 2023). One of the most important aspects of the genus Trichoderma is that all species have a great ability to parasitize and feed on phytopathogenic fungi, which is also known as mycoparasitism (Druzhinina et al., 2018; Harwoko et al., 2021). Parasitism is one of the main mechanisms involved in the antagonism of Trichoderma as a biocontrol agent. This complex process includes sequential events involving the cycle of fungal strain recognition by Trichoderma spp. First, it coils around the phytopathogen, then penetrates and feeds on it, and, finally, causes its death (Rajesh, Rahul, & Ambalal, 2016). Genome comparison of some Trichoderma species showed that a large portion of their genes encode parasitic action, suggesting that this is a common practice of that genus (Guzmán-Guzmán et al., 2023).
Parasitism begins in the rhizosphere of plants, where biocontrol is fundamental to preventing plant infection. First, recognition occurs between Trichoderma spp. and the pathogen, which is guided by the production of oligochitins and lectins as sensor molecules of Trichoderma spp. to carbohydrates in the pathogen’s cell wall. Prior to connecting with their host, various protease genes and oligopeptide transporters are expressed. Subsequently, Trichoderma coils around the body or hyphae of the pathogen; then, at the ends of its hyphae, guided by a protein (hydrophobin), structures called appressoria are formed, with which the antagonist penetrates the cell wall of the phytopathogen and, together with its hyphae called haustoria and the production of enzymes (such as cellulases, hemicellulases, chitinases, proteases and -1,3-glucanases, among other secondary metabolites essential for parasitism), it gives way to nutrient uptake (Bhat, 2017; Guzmán-Guzmán et al., 2023).
Trichoderma species not only parasitize fungi, but also root-knot nematodes and their eggs (Heidari & Olia, 2016). Hosts also generate reactive oxygen species and other metabolites in response to attack, while Trichoderma, in turn, activates genes involved in a detoxification response (Fang, Li, Zhao, & Zhao, 2021).
Antibiosis
Antibiosis is the process that involves the production and excretion of secondary metabolites called antibiotics, which are substances with cytotoxic activity, low molecular weight, or diffusible compounds, which interact and can limit or inhibit the growth of phytopathogenic microorganisms. This expression given by encoding genes increases when pathogens and plant compounds exert a signaling effect with the biocontrol agent (Dou et al., 2020; Alfiky & Weisskopf, 2021; Mukhopadhyay & Kumar, 2020). Low molecular weight diffusible compounds (which are secondary metabolites of antagonistic Trichoderma fungi) interact with, arrest growth or kill phytopathogenic hosts (Masi, Nocera, Reveglia, Cimmino, & Evidente, 2018). It is estimated that Trichoderma spp. are capable of biosynthesizing more than a thousand secondary metabolites (Zhang et al., 2021).
In 1932, Weindling isolated the first secondary metabolite obtained from Trichoderma lignorum (T. viride), a crystalline compound, antagonistic to other fungi, which was named glyotoxin, as well as another fungiastic compound named viridin with fungal activity. These metabolites are used in the biocontrol of phytopathogens (Mesa-Vanegas, Marín, & Calle-Osorno, 2019). Some Trichoderma species produce amino acids, such as α-aminoisobutyric acid (C4H9NO2), as an acetylated polypeptide antibiotic at its N-terminus and with an aminoalcohol at its C-terminus (Ramachander-Turaga, 2020). T. virens species produce trichodermamids, and T. koningii, koningininas, T. harzianum and T. virens synthesize azaphylones, harzianopyridone, harzianic acid and volatile terpenes, and different Trichoderma species produce a variety of hydrolytic enzymes and proteases, including exo- and endochitinases and exopeptidases, glucanases, lipases, and xylanases, which are involved in the biocontrol of pathogenic fungi with antifungal and antimicrobial action (Khan, Najeeb, Hussain, Xie, & Li, 2020; Sood et al., 2020). The best-known metabolite groups comprise non-ribosomal peptides such as peptaibiotics, siderophores, diketopiperazines, gliotoxin, glyoxin, gliovirin, polyketides, terpenes, pyrones, and isocyanate (Li, Li, & Zhang, 2019). Tables 2 and 3 show some secondary metabolites synthesized by Trichoderma.
Table 2 Secondary metabolites produced by Trichoderma fungi with antimicrobial activity and their hosts.
| Species | Class/Metabolite | Hosts | Reference |
|---|---|---|---|
| T. virens | Epipolythiodioxopiperazines / Gliotoxin and gliovirins | Rhizoctonia solani and Pythium ultimum | Patron et al. (2007) |
| T. polysporum | Polyketides / Antroquinonas | Fusarium spp. and Fomes annosus | Ghisalberti (1998) |
| T. harzianum, koningii and aureoviride | Polyketides / Konioginins | Phytophthora cinnamomi, Pythium middletonii, Rhizoctonia solani and Fusarium oxysporum | Lang et al. (2015) |
| T. harzianum, viride and atroviride | Pyrones / 6-pentyl- α-pyrone | Rhizoctonia solani and Fusarium moniliforme | Buchenauer & El‐Hasan (2009) |
| T. harzianum and virens | Pyrones / Massoilactone | Rhizoctonia bataticola and Fusarium | Dubey, Tripathi, Dureja, & Grover (2011) |
| T. virens and hamatum | Terpenoids / Viridiol | Aspergillus spp. and Rhizoctonia solani | Kerekes & Wipf (2003) |
| T. viride and virens | Terpenoids / Viridine | Fusarium caeruleum, Penicillium expansum and Aspergillus niger | Reino, Guerrero, Hernández-Galán, & Collado(2008) |
| T. harzianum | Hetrocyclic compounds / Harzianic acid | Sclerotinia sclerotiorum and Rhizoctonia solani | Vinale et al. (2009) |
| T. harzianum | Hetrocyclic compounds / Harzianopyridonone | Botrytis cinerea, Pythium ultimum and Gaeumannomyces graminis | Vinale et al. (2006) |
| T. asperellum and viride | Peptaibols / Trichotoxins | Staphylococcus aureus, Escherichia coli and Artemia salina | Ren et al. (2013) |
Table 3 Secondary metabolites produced by Trichoderma fungi with antifungal, antimicrobial, bioinductive and growth inhibitory activity.
| Species | Metabolite | Activity | Reference |
|---|---|---|---|
| T. koningiopsis | Trikoningin KB I | Antifungal | McMullin, Renaud, Barasubiye, Sumarah, & David (2017) |
| T. asperellum cf44-2 | Bisabolan-1,10,11-triol | Antibacterial | Song, Miao, Fang, Yin, & Ji (2018) |
| 12-nor-11-acetoxybisabolen-3,6,7-triol | Antibacterial and growth inhibitor | ||
| Dechlorotrichodenone C | |||
| T. saturnisporum | Saturnispol A, B, C, D, E, F, G and H | Antibacterial | Meng et al. (2018) |
| T. harzianum T4 | 2(5H)-furanone | Antifungal and growth inhibitor | Ahluwalia, Kumar, Rana, Sati, & Walia (2014) |
| 6-pentyl-2H-pyran-2-one | |||
| Palmitic acid | |||
| Stigmasterol | |||
| δ-decanolactone | |||
| Harzianopyridone | Antifungal | ||
| T. harzianum | Cyclo-(R-Pro-Gly) | Antibacterial | Li et al. (2019) |
| p-hydroxylphenylethanol | Antifungal | ||
| T. longibrachiatum | Sorbicillin | Antibacterial | Ji, Ma, & Miao (2014) |
| Ergosterol peroxide | |||
| Ergokonin A | Antifungal | ||
| T. viridescens TS0404 | α-phenylcinnamic acid | Antifungal | Zhang & Zhang (2015) |
| T. atroviride | 4H-1,3-dioxin-4-one-2,3,6-trimethyl | Antibacterial | Saravanakumar et al. (2019) |
| T. atroviride and T. harzianum | 1,3-dione-5,5-dimethylcyclohexane | Antibacterial | Saravanakumar et al. (2019) |
| T. atroviride S361 | Lignoren | Antibacterial | Kong et al. (2018) |
Competition for space and nutrients
In the rhizosphere, due to the secretion of substances (such as organic acids, amino acids and saccharides, among others) by plants and soil, microorganisms compete for food to survive, and those with the best metabolic capacity are in places where resources are abundant (Igiehon & Babalola, 2018). Thus, Trichoderma species that produce antagonistic compounds (such as antibiotics or lytic enzymes), and exhibit rapid growth and colonization strategies, can occupy the best spaces in the rhizosphere, restrict the development of other phytopathogenic microorganisms, and aid plant growth (He et al., 2022). This strategy is also used by plant growth promoting bacteria (PGPB), which have the ability to fix nitrogen, solubilize minerals, synthesize siderophores, produce auxins, gibberellins and cytokinins, manifest antagonistic activity against phytopathogens, and are efficient colonizers of the soil and rhizosphere for the benefit of plants; for this reason, it is important to carry out antagonism tests when selecting Trichoderma or PGPB biocontrol species to observe their synergy or rejection in relation to each other (Rodríguez et al., 2019; Aguilar-Benítez et al., 2020). The saprophytic character of T. spp. makes them useful in a wide variety of substrates to directly compete for nutrients (Hjeljord, Tronsmo, Harman, & Kubicek 1998). In soils rich in organic matter, this mechanism is less effective (Martínez, Infante, & Reyes, 2013). In addition, factors such as soil type, pH, temperature, and moisture must be considered to obtain satisfactory results in its application (Companioni-González at al., 2019).
Resistance induction
Microorganisms associated with plants in symbiosis, such as Trichoderma spp. or rhizobacteria, can induce plant defense systems, which is called systemic acquired resistance (SAR), and by modifying root biochemistry during their symbiotic interaction it is called Trichoderma-induced systemic resistance (TISR) and rhizobacteria-induced systemic resistance (RISR). This also happens when plants are attacked by pathogens or suffer mechanical damage, since systems are activated that enable them to protect themselves against disease or physical damage (Ab Rahman, Singh, Pieterse, & Schenk, 2018; Kumar, Kumari, Hembram, Kandha, & Bindhani, 2019).
Trichoderma spp. produce different metabolites that are important as inducers of resistance to phytopathogens of the plants with which they interact. Some examples of these metabolites are glucanases, lipoxygenases, chitinases, peroxidases (PODs), polyphenol oxidases (PPOs) and xylanases, among other protein-like gene products and low molecular weight compounds produced due to enzymatic-hydrolytic degradation of fungal or plant cells. These, together with the activation of transcription factors, make up the immune response that plants develop to biotic stress (Ahluwalia et al., 2014; Amorim et al., 2017).
TISR is very similar to RISR, in that both are regulated by the jasmonic acid/ethylene (JA/ET) signaling pathway. For example, T. hamatum strain Th23 can induce the expression of resistance proteins PR-1 and PR-7 in tomato plants following infection with tobacco mosaic virus (TMV) (Abdelkhalek, Al-Askar, Arishi, & Behiry, 2022; Risoli et al., 2022). Yedidia, Benhamou, and Chet (1999) observed increased resistance to phytopathogen attacks in cucumber (Cucumis sativus L.) roots inoculated with T. harzianum R. Likewise, T. hamatum TR 274 induces NPR1 gene activation in tomato plants during infection with TMV, which activates the SAR and RISR pathways with the production of enzymes (catalases, superoxide dismutases and PPO) and reduces hydrogen peroxide (H2O2) and malondialdehyde concentrations (Abdelkhalek et al., 2022).
T. harzianum R. induces chitinase expression in nightshades, making them tolerant to Rhizoctonia solani K. and Botrytis cinerea W. (Howell, 2003). T. atroviride synthesizes the volatile organic compound 6-pentyl-α-pyrone (6-PP), which contributes to better plant growth and regulates sugar transport (Esparza‐Reynoso et al., 2021). This and other compounds synthesized by Trichoderma spp. are shown in Table 4. Figure 1 shows the modes of action of Trichoderma spp. against pathogens and pests, as well as their presence in plants and soil.
Table 4 Compounds synthesized by Trichoderma considered as phytohormones that induce, in plants, growth, development and resistance to pathogens.
| Compound | Function | Inductor | Reference |
|---|---|---|---|
| Abscisic acid | Reduces transpiration and stomatal opening by inducing an ABA receptor | T. virens P. and T. atroviride P. | Contreras-Cornejo, Macias-Rodríguez, Cortés-Penagos, & López-Bucio (2009) |
| 3-gibberellic acid | Promotes growth and lowers the ethylene level | T. spp. | Hermosa et al. (2012) |
| Indoleacetic acid | Promotes plant growth and root development | T. virens P. | Contreras et al. (2009) |
| Jasmonic acid | Serves as a signaling agent for induced systemic resistance | T. asperellum S. L. & N. | Yoshioka, Ichikawa, Naznin, Kogure, & Hyakumachi (2012) |
| Salicylic acid | Improves disease resistance through SAR induction | T. atroviride P. | Meng et al. (2019) |
| Ethylene | Improves tolerance to biotic and abiotic stress by regulating SA and JA levels | T. atroviride P. | Wang, Li, & Ecker (2002) |
| Glucanases | Repel herbivores and plants, and protect against pathogens through biosynthesis of phenylpropanoids (phytoalexins) | T. spp. | Ahluwalia et al. (2014) |
| 6-pentyl-α-pyrone | Functions as a bio-based resistance inducer | T. atroviride UST2 | Esparza‐Reynoso et al. (2021) |
Trichoderma species consortia
Trichoderma spp. are important agricultural biocontrol microorganisms that are often used as effective components of fungicides, microbials and biofertilizers. However, most of these products are prepared with a single strain in monoculture, which significantly limits the biocontrol efficiency and stability of Trichoderma products. Therefore, research needs to be focused on the selection of consortia with Trichoderma strains for mixed cropping and to overcome the shortage of traditional Trichoderma-based biocontrol products (Hao et al., 2022).
Hao et al. (2022) measured the levels of antagonistic and growth-promoting activity in plants and in the germination of cucumber seeds infected with Fusarium oxysporum. The treatments were the combination of T. asperellum, T. asperelloides, T. harzianum and T. asperellum selected as a consortium in co-culture, versus monoculture of a single strain. It was observed that the consortia with multiple co-cultivated strains had better results and generated a greater amount of free amino acids than those of the monoculture. Also, the same results were obtained in another study with potted cucumber seedlings, where it was found that metabolites from co-cultures with mixed strains of Trichoderma species were better at promoting growth and eliminating or containing the pathogen than the single-strain monoculture.
Trichoderma species registered in Mexico
Currently, it is estimated that the diversity of fungi in the world ranges from 2.2 to 3.8 million species (Calaça et al., 2022), and just over 375 species of Trichoderma are accepted and can be identified by molecular phylogeny (Cai & Druzhinina, 2021) In Mexico, there are 18 autochthonous Trichoderma species registered in the NCBI GenBank and the European Nucleotide Archive (ENA), with 113 strains distributed in 11 states of the Mexican Republic (NCBI, 2021) (Table 5). According to several studies, it is possible that there are other variants of a species, and even other species that have not been recorded. Within the studies carried out in Mexico, Allende-Molar et al. (2022) point out that 42 species of the genus Trichoderma have been identified based on morphological characteristics. Of that number, the authors state that 17 have been identified at the molecular level, including T. asperellum S. L. & N. and T. harzianum R., the latter being the most marketed in biological products.
Table 5 Trichoderma species isolated in Mexico and registered in the GenBank database at the National Center for Biotechnological Information (NCBI) and in the European Nucleotide Archive (ENA) 2022 (https://eol.org/pages/6471602).
| No. | Isolated species | Identifier | Quantity and Mexican state of origin |
|---|---|---|---|
| 1 | Trichoderma avellanum (Rogerson & S.T. Carey) (Jaklitsch & Voglmayr) | TU11509 | One in Oaxaca |
| 2 | Trichoderma citrinoviride Bissett | MF078653 | One in Yucatán |
| 3 | Trichoderma hamatum (Bonord.) Bainier | MK791650 | One in Veracruz |
| 4 | Trichoderma intricatum Samuels & Dodd | HQ833351 | One in the State of Mexico |
| 5 | Trichoderma atroviride P. Karst | KR607462 | Two in Michoacán |
| 6 | Trichoderma gamsii Samuels & Druzhin | KR607467 | Two in Michoacán |
| 7 | Trichoderma ghanense Yoshim Doi, Y. Abe & Sugiyama | MF078652 | One in Quintana Roo and one in Yucatán |
| 8 | Trichoderma longibrachiatum Rifai | HQ833356 | Two in the State of Mexico |
| 9 | Trichoderma paravidescens Jaklitsch, Samuels & Voglmayr | JX144329 | One in the State of Mexico and two in Tabasco |
| 10 | Trichoderma tomentosum Bissett | KR607480 | Four in Michoacán |
| 11 | Trichoderma koningii Oudem | HQ833349 | Two in the State of Mexico and two in Michoacán |
| 12 | Trichoderma virens J.H. Miller, Giddens & A.A. Foster | KT923710 | One in Sinaloa and four in Yucatán |
| 13 | Trichoderma koningiopsis Samuels, C. Suárez & H.C. Evans | MK791649 | One in Puebla, one in Yucatán, four in Jalisco and one in the State of Mexico |
| 14 | Trichoderma viridescens (A.S. Horne & H.S. Will.) (Jaklitsch & Samuels) | KR607474 | Six in Michoacán |
| 15 | Trichoderma asperellum Samuels, Lieckf. & Nirenberg | KT923711 | One in Yucatán, two in Sinaloa and four in Michoacán |
| 16 | Trichoderma viride Pers | HQ833348 | One in Colima, one in Veracruz and five in the State of Mexico |
| 17 | Trichoderma eijii C.S. Kim & N. Maek | KX953405 | One in Nayarit and 23 in Veracruz |
| 18 | Trichoderma harzianum Rifai | MF078650 | 28 in Michoacán, four in Yucatán and two in the State of Mexico |
Commercial products
In 80 years of use in Mexico, there are 230 biological control bioproducts produced by 40 companies that are registered with the Federal Commission for Protection against Sanitary Risks (Comisión Federal para la Protección contra Riesgos Sanitarios; COFEPRIS), but some of them have a limited number of taxonomic groups in their active compounds, such as Trichoderma spp., where T. harzianum, T. virens, T. asperellum and T. gamsii stand out for their commercial agricultural use in Mexico (COFEPRIS, 2021). T. harzianum is the most marketed biological control species, and Sinaloa is the leading producer and marketer (Magalhães-de Abreu & Heinrich, 2022). Reports on biological control of phytopathogens at a national scale indicate limited availability of Trichoderma spp. as a biopesticide in pest control in Mexico (Córdova-Albores et al., 2021). Table 6 shows some Trichoderma spp.-based products available in Mexico, and Table 7 shows Trichoderma spp.-based products produced in different countries.
Table 6 Commercial products made from Trichoderma available in Mexico.
| Product/Species | Diseases/Pathogens | Crops | Sources |
|---|---|---|---|
| TUSAL® / | Of the root and damping off / Fusarium spp. and Rhizoctonia solani | Tomato, peppers, cucurbits and beet | Timac Agro (2022) (2022) |
| T. atroviride T-11 T. asperellum T-25 | |||
| ProSelectiv® / | Of the root and damping off / Macrophomina phaseolina, Phymatotrichum omnivorum, Armillaria spp., Phomopsis spp., *Botrytis cinerea and Nectria galligena | Cucurbits, grapevine, walnut, pea, banana, strawberry, brassicas, flowers, peach, nightshades and apple tree | Azul Natural (2021) |
| T. harzianum | |||
| Don Jon® / | Of the root, damping off and cut wounds / Yesca, *Verticillium spp., Sclerotium rolfsii, Phytophthora spp., Thielaviopsis spp., *Nectria galligena, Rhizoctonia purpureum and Pythium spp. | Fruit trees, forestry, strawberry, grapevine, celery, endive, artichoke, olive, carrot, ornamentals, eggplant, tomato and spinach | Bayer (2021) |
| T. asperellum ICC012 T. gamsii ICC080 | |||
| Funqui Q07® / | Of the root and damping off / Phytophthora spp., Fusarium spp., Cylindrocladium spp. and Thielaviopsis sp. | Tomato, eggplant, tobacco, tomatillo, peppers, agaves, potato, jalapeño and habanero | Quimia (2022) |
| T. viride Q07 | |||
| Spectrum Trico-Bio® / | Of the root, damping off and neck rot / Peronospora destructor, Phytophthora parasítica, Pseudocercospora opuntiae, Colletotrichum gloeosporioides, Rhizoctonia sp. and Fusarium oxysporum | Tomato, nopal, raspberry, papaya, cucurbits, pineapple, strawberry, asparagus, tomatillo, garlic and habanero | PTI (2022) |
| T. harzianum | |||
| RootShield Plus® / | Of the root and damping off / Phytophthora spp., Pythium spp., Cylindrocladium spp., Fusarium spp., Rhizoctonia spp. and Thielaviopsis spp. | Blueberry, raspberry, strawberry, eggplant, tomatillo, potato, peppers, tobacco, blackberry and tomato | PHCa (2021) |
| T. harzianum T-22 T. virens G41 | |||
| Phc T22® / | Prevents root pathogens in all types of climates and soils / Pythium spp., Thielaviopsis spp., Rhizoctonia spp., Cylindrocladium spp., Fusarium spp. and Sclerotinia sclerotiorum | Cucurbits, nightshades, onion, asparagus, strawberry, blackberry, raspberry and elmleaf blackberry | PHCb (2021) |
| T. harzianum T-22 T. harzianum KRL-AG2 | |||
| Trianum P® / | Of the root and damping off / Fusarium spp., Rhizoctonia spp., Sclerotinia spp. and Phytophthora spp. | Cereals, vegetables, grasses, arboriculture, perennial fruit trees and corn | Koppert (2021) |
| T. harzianum T-22 | |||
| Labrador® / | Of the root and neck rot / Phytophthora cinnamomi, Phymatotrichopsis omnívora, *Verticillium spp., Sclerotinia sclerotiorum, Thielaviopsis spp., Pyrenochaeta Terrestre, Rhizoctonia solani and Cylindrocladium spp. | Walnut, avocado, onion, strawberry, berries, cucurbits and nightshades | Versa (2021) |
| T. harzianum | |||
| Tricho-sin® / | Of the root and damping off / Colletotrichum spp. and Fusarium spp. | Mango, peppers, leek, grapevine, nightshades, kiwi, strawberry, onion, cucurbits and asparagus | Agrobionsa (2022) |
| T. harzianum ABNTh 502 | |||
| Biotricho-H. / | Of the root and damping off / Fusarium spp. and Rhizoctonia spp. | Cucurbits, nightshades, avocado, peppers | Sagana Agrobiológicos (2022) |
| T. harzianum | |||
| Bioben / | Of the root and damping off / Phytophthora spp., Rhizoctonia spp., Pythium spp., Sclerotinia spp., Sclerotium spp., Fusarium spp. and Verticillium spp. | Mango, peppers, cucurbits, nightshades | Innovación Agrícola (2022) |
| T. harzianum |
*Product applied to the foliage
Table 7 Commercial products made from Trichoderma species from some countries.
| Product/Species | Diseases/Pathogens | Crops | Reference | Country |
|---|---|---|---|---|
| ECO-T® / | Root promoter / Pythium spp., Rhizoctonia spp., Phytophthora spp. and Fusarium | Vegetables and fruit trees | Andermatt Madumbi (2022) | South Africa |
| Trichoderma asperellum | ||||
| TRICHODERMAX EC® / | Of the stem and root / Sclerotinia sclerotiorum, Fusarium solani and Rhizoctonia solani | Bean and soybean | Agro Link (2022) | Brazil |
| Trichoderma asperellum | ||||
| ECOHOPE®ECOHOPE-DRY® / | Of the foliage, stem and root / Gibberella fujikuroi, Burkholderia plantarii, Burkholderia glumae and Acidovorax avenae | Rice | Kumiai Chemical Industry (2022) | Japan |
| Trichoderma atroviride and SKT-1 | ||||
| AGRODERMA® / | Vascular (root and stem) / Rhizoctonia solani, Pythium spp., Phytophthora spp., Verticillium spp., Fusarium spp., Sclerotinia spp. and Sclerotium rolfsii | Tomato, pepper, potato, eggplant and tobacco | Gruindag International (2022) | Mexico |
| Trichoderma harzianum | ||||
| BIO-T® / | Overturning or damping off / Rhizoctonia solani and Fusarium spp. | Rice | P.L.A. Biológico (2022) | Colombia |
| Trichoderma harzianum | ||||
| BIOHARZ® / | Of the root or damping off / Fusarium, Rhizoctonia, Pythium, Sclerotium spp., Verticillium spp., Alternaria spp. and Botrytis cinerea | Cereals, pulses, seeds, oilseeds, cotton, nightshades, potato, onion and coffee | FARMERSSTOP (2022) | India |
| Trichoderma harzianum | ||||
| HULKGREEN® / | Of the root or damping off / Rhizoctonia, Sclerotinia, Pythium, Fusarium, Verticillium, Puccinia, Phytophthora and Peronospora | Vegetables and fruit trees | Caltech S.A. (2022) | Argentina |
| Trichoderma harzianum | ||||
| LYCOMAX® / | Of the root or damping off / Pythium spp., Phytophthora spp., Rhizoctonia spp. and Fusarium spp. | Tubers and ornamentals | Russell IPM. (2022) | United Kingdom |
| Trichoderma harzianum | ||||
| NATUCONTROL® / | Of the root, stem and neck / Phytophthora capsici, Fusarium oxysporum and Sclerotinia spp. | Tomato, lettuce, avocado, strawberry, peanuts, legumes, jicama and soybean | Biokrone (2022) | USA |
| Trichoderma harzianum | ||||
| SOILGARD 12 G® / | Overturning / Phytophthora capsici, Fusarium oxysporum, Sclerotinia sp. and Phytophthora cinnamomi | Nightshades, cucurbits, ornamentals, lettuce, spinach | Certis (2022) | USA |
| Trichoderma virens and Gliocladium virens GL-21 | ||||
| ASTHA TV® / | Of the neck and root / Rhizoctonia solani, Pythium spp. and Fusarium spp. | Fruit trees, vegetables, turmeric and spices | Lila Agrotech (2022) | India |
| Trichoderma viride | ||||
| CONTEGO TR® / | Of the root, seeds and defense inductor / Rhizoctonia, Pythium and Armillaria | Fruit trees, vegetables, legumes and oilseeds | Biological Solutions (2022) | New Zealand |
| Trichoderma viride | ||||
| FUNGISTOP® / | Of the root, stem and foliage / Fusarium spp., Pythium spp., Alternaria spp., Verticillium spp., Erysiphe spp., Peronospora spp., Botrytis spp. and Helminthosporium | Fruits, nightshades, cucurbits and berries | Biona (2022) | Russia |
| Trichoderma viride | ||||
| BIOSPARK® / | Biofertilizer and growth promoter / Phytophthora spp. | Corn, rice, vegetables, mango, banana, sugarcane and pineapple | Biospark Corp. (2022) | Philippines |
| Trichoderma spp. | ||||
| TRICODAMP® / | Overturning or damping off / Phytophthora spp., Rhizoctonia spp. and Pythium spp. | Extensive crops, vegetables and fruit trees | Probiotec (2022) | Bolivia |
| Trichoderma spp. | ||||
| VALERY PLUS® / | Overturning or damping off / Rhizoctonia spp., Botrytis cinerea and Phytophthora spp. | Fruit trees and grapevine | Agrobioticos (2022) | Peru |
| Trichoderma harzianum and Trichoderma viride | ||||
| NUTRI-LIFE TRICHO- SHIELD® / | Plant growth promoter seeds and transplants / Phytophthora spp. | Bulbs, cuttings, grafts and established crops | Nutri-Tech Solutions (2022) | Australia |
| Trichoderma harzianum, T. lignorum and T. koningii | ||||
| 3 TAEX® / | Stem rot / Chondrostereum and Heterobasidium | Fruit trees, strawberry and Pinus radiata | Pinturas Renner Biotechnologies (2022) | Chile |
| T. viride, T. harzianum and T. longibrachiatum |
Conclusions and recommendations
The positive biological effects of the antagonistic fungus Trichoderma on plants have been proven, not only in the laboratory but also in the production of agricultural crops in greenhouses. Due to its efficient broad-spectrum antimicrobial activity, Trichoderma has established itself as an internationally recognized biocontrol agent. However, field studies are required to determine the doses and timing for the application of Trichoderma species that can act in combination.
According to the analysis in this review, Trichoderma species are beneficial and essential to keep plants and soil in ideal conditions for agriculture. This paper describes, in a simplified manner, the ways to obtain, isolate and identify Trichoderma strains, including biocontrol mechanisms related to antibiosis, mycoparasitism, induced resistance in plants, and competition for space and nutrients.
Currently, there is a growing number of reports on Trichoderma species that evaluate their antagonistic activity and their use as a biocontrol method for combatting phytopathogens in commercially important crops.
In different regions of Mexico, and with the aim of promoting sustainable agriculture, various biopreparations based on a few species of Trichoderma are marketed, mainly T. harzianum, followed by T. virens, T. asperellum and T. viride.
It is important to emphasize that with the information provided in this review on the biocontrol of native Trichoderma species registered in Mexico, as well as the description of the action and availability of products based on Trichoderma spp., interest can be generated in their use by farmers, as well as new research alternatives with guidelines that contribute to the transfer of biocontrol knowledge. The foregoing considers the use of different Trichoderma species to develop more effective commercial products against local phytopathogenic fungi, for the benefit of quality agriculture and pesticide-free crops.
It is necessary to promote information on the use and availability of Trichoderma species among farmers and to popularize their use, as well as to boost research on the management of native species in crops of agricultural and forestry interest, both in vitro and in situ. For this reason, it is necessary to support the institutions and laboratories dedicated to this field.
Also, research on the ecological effects of widespread applications of one or some Trichoderma species in an agricultural consortium should be expanded, in order to guarantee an effect that benefits the environment.
At present, molecular techniques are required for accurate identification, both at the species level and for the classification of isolates in the genus Trichoderma. However, in addition to DNA or RNA sequencing, new advances and changes that occur year after year should be taken into account.
Due to the growing number of commercial products for a great diversity of crops, as well as the finding of new strains in the geographical distribution of Mexico, it is necessary to select fungal strains for multiple use and test whether they are effective or superior as mycoparasites, whether they promote systemic plant resistance to abiotic and biotic stress, whether they promote plant growth and development to increase yields, and whether they persist in the rhizosphere and are endophytes. This information could be used to identify products that are actively sought after by agriculture.










texto en